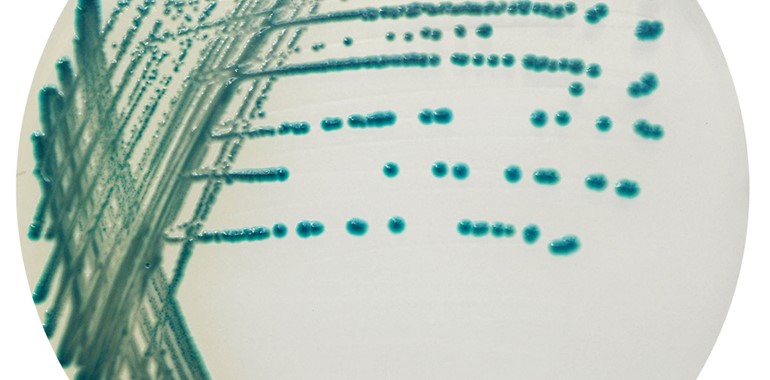

CHROMagar Serratia
Chromogenes Medium zum Nachweis von Serratia marcescens.
Serratia-Arten sind immer häufiger Ursache nosokomialer Infektionen. In vielen Ländern kommen Serratia marcescens-Infektionen in Verbindung mit Epidemien auf Intensivstationen - und insbesondere auf Neugeborenen- und Kinderstationen - vor. Die Überwachung nosokomialer Infektionen erfordert eine effektive Anreicherung klinischer Isolate aus Fäkalien, Wundexsudaten sowie respiratorischen Proben, um solche Infektionen zu verhindern.
CHROMagar™ Serratia eignet sich daher sehr gut für den Nachweis von S. marcescens:
- Verlässlich: Erstes kommerzielles chromogenes Medium zum Nachweis von S. marcescens.
- Spezifisch: Sensitivität und Selektivität für S. marcescens über 97 %*.
- Einfaches Ablesen: Intensive grün-blau Kolonien erleichtern das Ablesen.
- Schnelle Ergebnisse: Ablesen der Platten nach 18 – 24 Stunden.
*Daten aus der Studie «Validation of Colorex™ (CHROMagar™) Serratia agar on WASP™/WASPLab™ in screening for Serratia marcescens in neonatal intensive care units using the ESwab™» M. Gaskin, D. Yamamura, J. Korver, 2020.